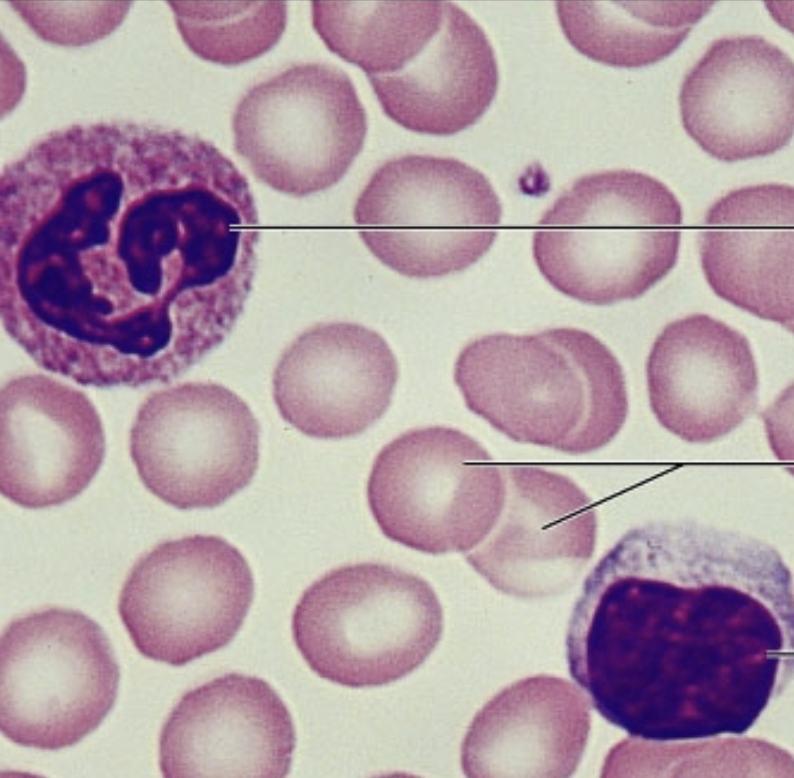
term image

1/74
Epithelium, Connective Tissue, Muscle Tissue, and Nervous Tissue
Name | Mastery | Learn | Test | Matching | Spaced | Call with Kai |
|---|
No study sessions yet.

simple squamous epithelium

simple squamous epithelium

simple squamous epithelium
Location:
Function:
of simple squamous epithelium
Location: Lungs
Function: single layer of flatten cells allow for easier diffusion and filtration in sites

simple cuboidal epithelium

simple cuboidal epithelium

simple cuboidal epithelium

simple cuboidal epithelium
Location:
Function:
of simple cuboidal epithelium
Location: Kidney Medulla
Function: secretion and absorption

Simple columnar epithelium
Location:
Function:
of simple columnar epithelium
Location: stomach
Function: Absorption, secretion of mucus, enzymes, and other substances

Pseudostratified ciliated columnar epithelium

Pseudostratified ciliated columnar epithelium

Pseudostratified ciliated columnar epithelium
Location:
Function:
of Pseudostratified ciliated columnar epithelium
Location: respiratory tract
Function: secretes substances, specifically mucus

Stratified squamous epithelium

Stratified squamous epithelium
Location:
Function:
of Stratified Squamous Epithelium
Location: esophagus
Function: Protects underlying tissues in areas subjected to abrasion

Stratified Cuboidal Epithelium

Stratified Cuboidal Epithelium
Location:
Function:
of Stratified Cuboidal Epithelium
Location: sweat gland
Function: Protection

Stratified Columnar Epithelium

Stratified Columnar Epithelium
Location:
Function:
for Stratified Columnar Epithelium
Location: Parotid gland
Function: secretion

Transitional Epithelium

Transitional Epithelium

Transitional Epithelium
Location:
Function:
for Transitional Epithelium
Location: Ureter, Bladder
Function: Stretches readily, permits the storage of urine to distend the urinary organ

Areolar connective tissue

Areolar connective tissue

Areolar connective tissue

Areolar connective tissue
Location:
Function:
for Areolar connective tissue
Location: Found under the epithelium tissue of body
Function: wraps and cushions organs

Adipose connective tissue

Adipose connective tissue

Adipose connective tissue
Location:
Function:
for adipose connective tissue
Location: Found under skin in subcutaneous tissue, within abdomen
Function: Provides food reserve, insulation, and protects organ

Reticular connective tissue

Reticular connective tissue

Reticular connective tissue
Location:
Function:
for reticular connective tissue
Location:spleen
Function: Fiber’s form a soft internal skeleton that supports other cell types

Dense regular connective tissue

Dense regular connective tissue
Location:
Function:
for dense regular connective tissue
Location: tendons
Function: attachment and withstand tensile strength

dense irregular connective tissue
Location:
Function:
for dense irregular connective tissue
Location: dermis of skin
Function: withstand tension and provide structural strength

Elastic Connective tissue

Elastic connective tissue
Location:
Function:
for elastic connective tissue
Location: wall of arteries
Function: allow tissue to recoil after stretching and maintaining blood flow through arteries
Blood connective tissue
Location:
Function:
for Blood connective tissue
Location: blood vessels
Function: transport respiratory gasses, nutrients, wastes, and other substances

Hyaline cartilage connective tissue

Hyaline cartilage connective tissue
Location:
Function:
for Hyaline connective tissue
Location: covering the long ends of long bones, cartilages of the nose, trachea, etc
Function: support, cushion, and resist stress

Elastic cartilage is connective tissue

Elastic cartilage connective tissue
Location:
Function:
for elastic cartilage connective tissue
Location: support the external ear; epiglottis
Function: maintain shape and allows for flexibility

fibrocartilage connective tissue

fibrocartilage connective tissue

fibrocartilage connective tissue
Location:
Function:
for fibrocartilage connective tissue
Location: found in intervertebral discs, pubic symphysis; discs of knee joint

Bone connective tissue

Bone connective tissue
Location:
Function:
for bone connective tissue
Location: bones
Function: supports and protects, stores calcium and other minerals, and is involved in red blood cell production

skeletal muscle

skeletal muscle
Location:
Function:
for skeletal muscle
Location: in the skeletal muscle attached to bones or skin
Function: produce voluntary movement

Cardiac muscle

Cardiac muscle
Location:
Function:
for Cardiac muscle
Location: in the wall of the heart
Function: produce involuntary movement

Smooth muscle

smooth muscle
Location:
Function:
for smooth muscle
Location: walls of hallow organs (digestive organs)
Function: produce involuntary movement

Neurons
Location:
Function:
for neurons
Location: in the brain, spinal cord, and nerves
Function: Neuron= can’t regenerate and Neuroglia= can regenerate